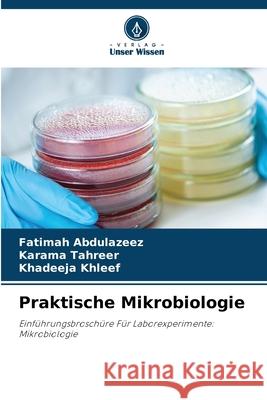
Praktische Mikrobiologie Abdulazeez, Fatimah, Tahreer, Karama, Khleef, Khadeeja 9786208767518 Verlag Unser Wissen - książka

Praktische Mikrobiologie » książka
Praktische Mikrobiologie
ISBN-13: 9786208767518 / Niemiecki / Miękka / 2025 / 60 str.
Das Buch ist ein Laborhandbuch, das sich auf mikrobiologische Experimente konzentriert, insbesondere auf die Identifizierung und Charakterisierung von Mycobacterium-Arten, einschließlich M. tuberculosis. Es enthält verschiedene Tests wie den Neutralrot-Test, die Katalaseaktivität, die Anfälligkeit für Pyrazinamid, den Amidase-Test und den Nitratreduktionstest, in denen die biochemischen Eigenschaften dieser Bakterien detailliert beschrieben werden. Darüber hinaus werden bakterielle Filtrationsmethoden, die Verwendung von Desinfektionsmitteln wie Ethanol und Isopropanol sowie Strahlung zur Sterilisierung erörtert. Insgesamt dient es als praktischer Leitfaden für Studenten und Forscher in der Mikrobiologie.